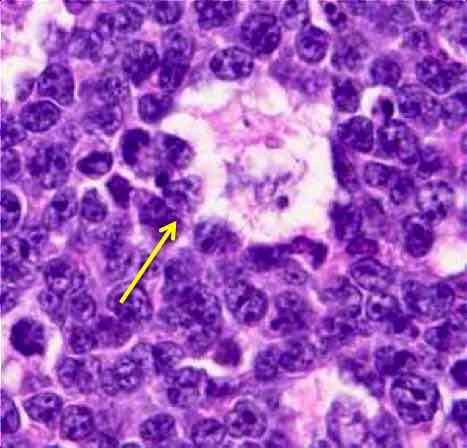
Lenf Şişliği Lenfoma Olabilir

Bir Dakikalık Radyoterapi

Kanser tedavisinde yüksek teknolojinin kullanılması, hem hastalara verilen hizmetin kalitesini artırıyor, hem de tedavisi süresini kısaltıyor. “Rapidarc Teknolojisi” ile radyoterapi süresi bir dakikaya iniyor.
Prof. Dr. Enis Özyar
Radyasyon Onkolojisi Uzmanı
Son yıllarda radyoterapi tedavisinde standart olarak lineer hızlandırıcı denilen cihazlar kullanılmaktadır. Bu cihazlar x-ışınları üretip hastalıklı bölgeye belli bir tedavi planlaması dahilinde uygulanmaktadır. Tedavi edici ışınlar hastalara belli bir mesafeden uygulanmakta ve hastaların tedavi hassasiyeti açısından tedavi süresince hareketsiz kalmaları istenmektedir.
Tedavi edilen bölgeye göre baş boyun bölgesinde özel termoplastik maskeler, diğer bölgelerde özel tedavi yatakları ve hareketsizleştirici cihazlar kullanılmaktadır. Tedaviler genellikle 5-10 dakika sürmektedir. Son yıllarda normal dokulara olan zararı en aza indirgemeye yönelik olarak kullanılmaya başlanan IMRT (Yoğunluk ayarlı radyoterapi) uygulamalarında ise bu süre 15-30 dakika arasında değişebilmektedir.
Ülkemizde de kullanılmaya başlanan IGRT (Görüntü Kılavuzluğunda Radyoterapi) ile bu süreler 4-5 dakika uzamaktadır. Bu süredeki uzamanın nedeni hastanın her seansta görüntüleme ile tedavi bölgensin kontrol edilmesi ve takiben ışınlanmasını sağlayan gelişmiş teknolojinin kullanılmasıdır. Son yıllarda kullanılmaya başlanan Tomotherapy adı verilen IGRT özellikli Bilgisayarlı Tomografi benzeri radyoterapi cihazında ise tedavi süreleri 20-40 dakika arasında değişmektedir.
Hastaların bu kadar uzun süre hareketsiz yatmaları genellikle çok güç olmaktadır. Sağlıklı bir bireyin bile bu kadar uzun süre hareketsiz yatmasını bekleyemeyiz. Hastalarımızda özellikle tedavi yan etkilerde arttıkça hareketsiz yatabilmek gittikçe zor hale gelmektedir. İşte bu durumlarda tedavi süresinin kısa olması büyük önem taşımaktadır.
2- Rapidarc teknolojisi hakkında bilgi verir misiniz? Ne amaçla kullanılıyor?
İşte Rapidarc teknolojisi bu süreyi ciddi anlamda düşüren en yeni teknoloji tedavi cihazıdır. Hastalarda IGRT süresi 2 dakikaya inmekte, tedavi süresi ise yine 2 dakikada tamamlanmaktadır. Bu da toplam hastanın tedavi masasında kalma süresini toplam 6-8 dakikaya indiren bir tedaviye neden olmaktadır. 30-45 dakikalık tedavi sürelerinden 6-8 dakikalık sürelere gelinmesi hep bize yüksek teknolojilerin getirdiği gelişmelerdir.
3 – Özellikleri nelerdir?
Eski teknolojilerde tedavi cihazı hasta etrafında belli açılarda dönüp durduktan sonra ışınlama yapmaktaydı. Rapidarc teknolojisinde tedavi cihazı hasta etrafında dönerken ışınlama yapabilme özelliğine sahip olmaktadır. Kısaca Rapidarc’ı 2 dakikada IGRT yapan, 2 dakikada IMRT yapan bir cihaz olarak tanımlamak mümkündür.
4 -Hangi kanser türlerinde ve hangi evrelerde kullanıyorsunuz?
Bu teknoloji tüm kanser türlerinde ve radyoterapi uygulanan tüm hastalarda kullanılmaktadır.
5-Dünyada yaygın bir teknoloji mi? Türkiye’de yaygınlığı anlamında bir durum değerlendirmesi yapabilir misiniz?
Bu cihaz ilk kez Ocak 2008 tarihinde ABD’de FDA onayı aldıktan sonra Avrupa’da 3 merkezde, ABD de 5 merkezde deneme amaçlı kullanılmaya başlanmıştır. Yapılan çalışmalarda tedavi sonuçları Ekim 2008 tarihinde yapılan uluslararası kongrelerde sunularak son derece başarılı olduğu görülmüştür.
6- Böyle bir teknolojiye neden ihtiyaç duyuldu?
Bu teknolojiye ihtiyaç duyulmasının en büyük nedeni hastaların tedavi konforudur. Tabi tedavi süresinin 30 dakikadan 8 dakikaya inmesi ile tedavi cihazında daha çok hastamızı tedavi etme olanağını da yaşayacağız.
7- Çalışma prensipleri nelerdir? Hastalara faydası nedir?
Rapidarc teknolojisi Hacimsel Yoğunluk Ayarlı Arc tedavisi olarak adlandırılan bir tedavi cihazıdır. Bu cihazda tedavi makinesi diğer cihazların aksine hasta etrafında dönerken yani hareketli iken ışınlama yapma olanağı sağlamakta, tedavinin hızlı bir şekilde hastanın hareket etmesine fırsat vermeden yapılmasını sağlamaktadır.